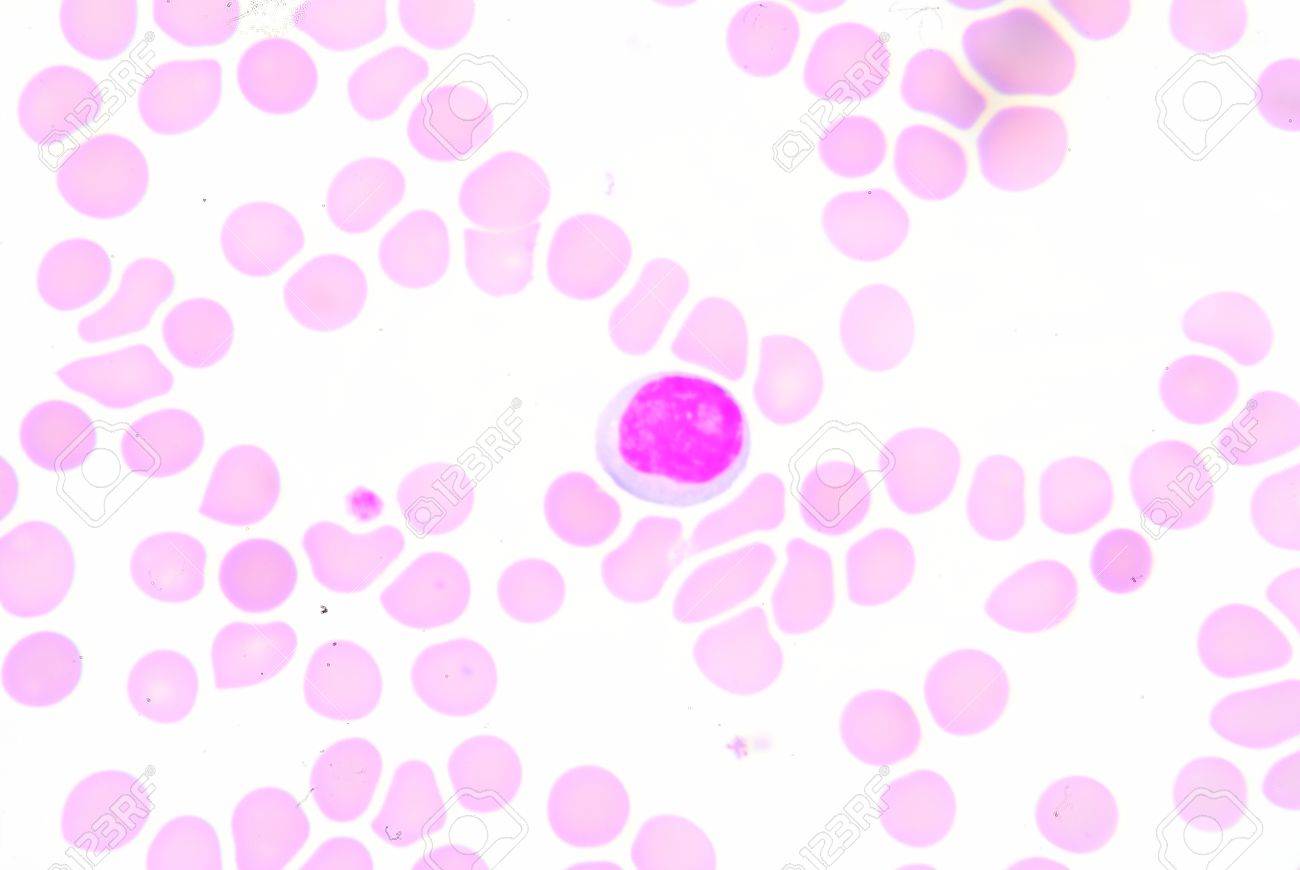
etiam-dictum-ipsum-a-felis

Download
Close
Автор:
id:
Ключевые слова:
antibodies, antigen, b cells, biology, blood, bloodstream, cells, circulatory system, deactivation, health, health care, hematology, human, immune response, immune system, immunity, leucocyte, leukocyte, lymph nodes, lymphocyte, lymphoid, medical, medicine, microbiology, microscopic, natural killer cells, on white, organism, pathology, receptors, science,





